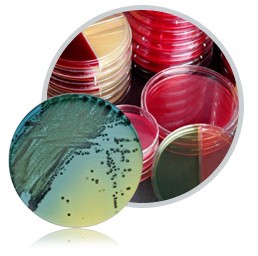

西宝生物科技(上海)股份有限公司
客服电话:400-021-8158
公司传真: 021-50272982
公司邮箱:
market@seebio.cn
公司地址:总部:中国(上海)自由贸易试验区毕升路299弄11号502室 邮编:201204
研发生产中心:上海市浦东新区川宏路508号5幢 邮编:201202
-

-
癌症与肿瘤标志物解决方案
肿瘤标志物或不存在于正常成人组织而仅见于胚胎组织,或在肿瘤组织中的含量大大超过在正常组织里的含量,它们的存在或量变可以提示肿瘤的性质,借以了解肿瘤的组织发生、细胞分化、细胞功能,以帮助肿瘤的诊断、分类、预后判断以及治疗指导。
-

-
微生物培养基解决方案(1)------Nissui培养基
Nissui(日水)产品广泛用于细胞培养、活体菌总体计数、食品卫生及环境检测等。质量优越,特别在细胞培养的后期传代体现其优势。
-
-
细胞培养基解决方案(2)------Gibco培养基
Gibco细胞培养基系列产品包含设计用来支持和维持细胞系生长的产品,适用于各种哺乳动物细胞和细胞系,这一点经过了时间的检验与验证。Gibco已经开发出的即用型培养基产品包含粉末和浓缩液两种形式,可以满足你实验建立和预算的双重需要。
-

-
地鼠肾细胞培养狂犬病疫苗生产的解决方案
狂犬病作为危害人类健康的古老的疾病之一,流行于世界大多数的国家和地区。据统计,每年都有不少于4000 人死于狂犬病发作。狂犬病疫苗作为对抗狂犬病的有效方法也随之经历了漫长的发展过程。目前世界上存在很多狂犬病疫苗的生产技术,介绍了应用细胞毒株制备狂犬病地鼠肾细胞纯化疫苗的解决方案。
-

-
脑损伤标志物解决方案
脑损伤是当前严重危及青壮年健康和生命的主要问题。脑损伤标志物,或称“脑的生物标志物”,是当前医学发展所关注的热点之一。它是指在脑组织发生损伤或有脑血管病时,在患者血或脑脊液中出现的可测定的、具有标志性的指标。
-

-
茶叶多糖检测解决方案
茶多糖(Tea polysaccharides,简称TPS)是茶叶中具有特殊生物活性的一类与蛋白质结合在一起的酸性多糖或酸性糖蛋白。药理研究表明,茶多糖具有显著的降血糖效果和免疫活性,使茶多糖有望成为预防与治疗糖尿病和心血管疾病、提高免疫功能的天然药物。
-

-
疫苗分离纯化技术解决方案
疫苗生产过程中不可避免的有一些杂质,如细菌菌体、细胞碎片、血清、杂蛋白、核酸等。为了得到具有高纯度、无菌性和安全性的疫苗,要除去这些杂质。
-

-
埃博拉病毒检测解决方案
埃博拉病毒是引起人类和灵长类动物发生埃博拉出血热(EBHF)的烈性传染病病毒,其致死率高达50%至90%,是当今世界上致命的病毒性出血热,感染者症状与同为纤维病毒科的马尔堡病毒极为相似,人类感染埃博拉病毒几天后会出现发烧、头疼、关节和肌肉及喉咙疼痛、周身虚弱等症状,许多患者还会出现体内或体外出血;另有人打嗝、眼睛又红又痒。感染一周后病人会胸痛、休克,甚至死亡。
-

-
中药材中黄曲霉毒素整体解决方案
黄曲霉毒素具有较强致癌性,它们是一类真菌(如寄生曲霉和黄曲霉等)的有毒代谢产物,主要存在于药材、谷物、坚果、棉籽以及动物饲料等中。毒素远高于氰化物、砷化物和有机农药的毒性,其中以B1毒性较大。当人摄入量大时,可发生急性中毒,出现急性肝炎、出血性坏死、肝细胞脂肪变性和胆管增生。当微量持续摄入,可造成慢性中毒,生长障碍,引起纤维性病变,致使纤维组织增生。针对真菌检测监控体系的日益完善及其检测需求的不断增加,西宝生物近期推出了中药材中黄曲霉毒素检测整体解决方案,供广大实验者参考。
-

-
可溶性抗原的制备及鉴定解决方案
蛋白质、糖蛋白、脂蛋白、酶类、补体、脂多糖、细菌外毒素和核酸等均为可溶性抗原,它们有相当部分来源于组织和细胞,成分复杂。制备这类免疫原时,首先须将组织和细胞破碎,然后再从组织和细胞匀浆中提取目的蛋白或其他抗原,提纯的抗原需鉴定后才能用做免疫原。






